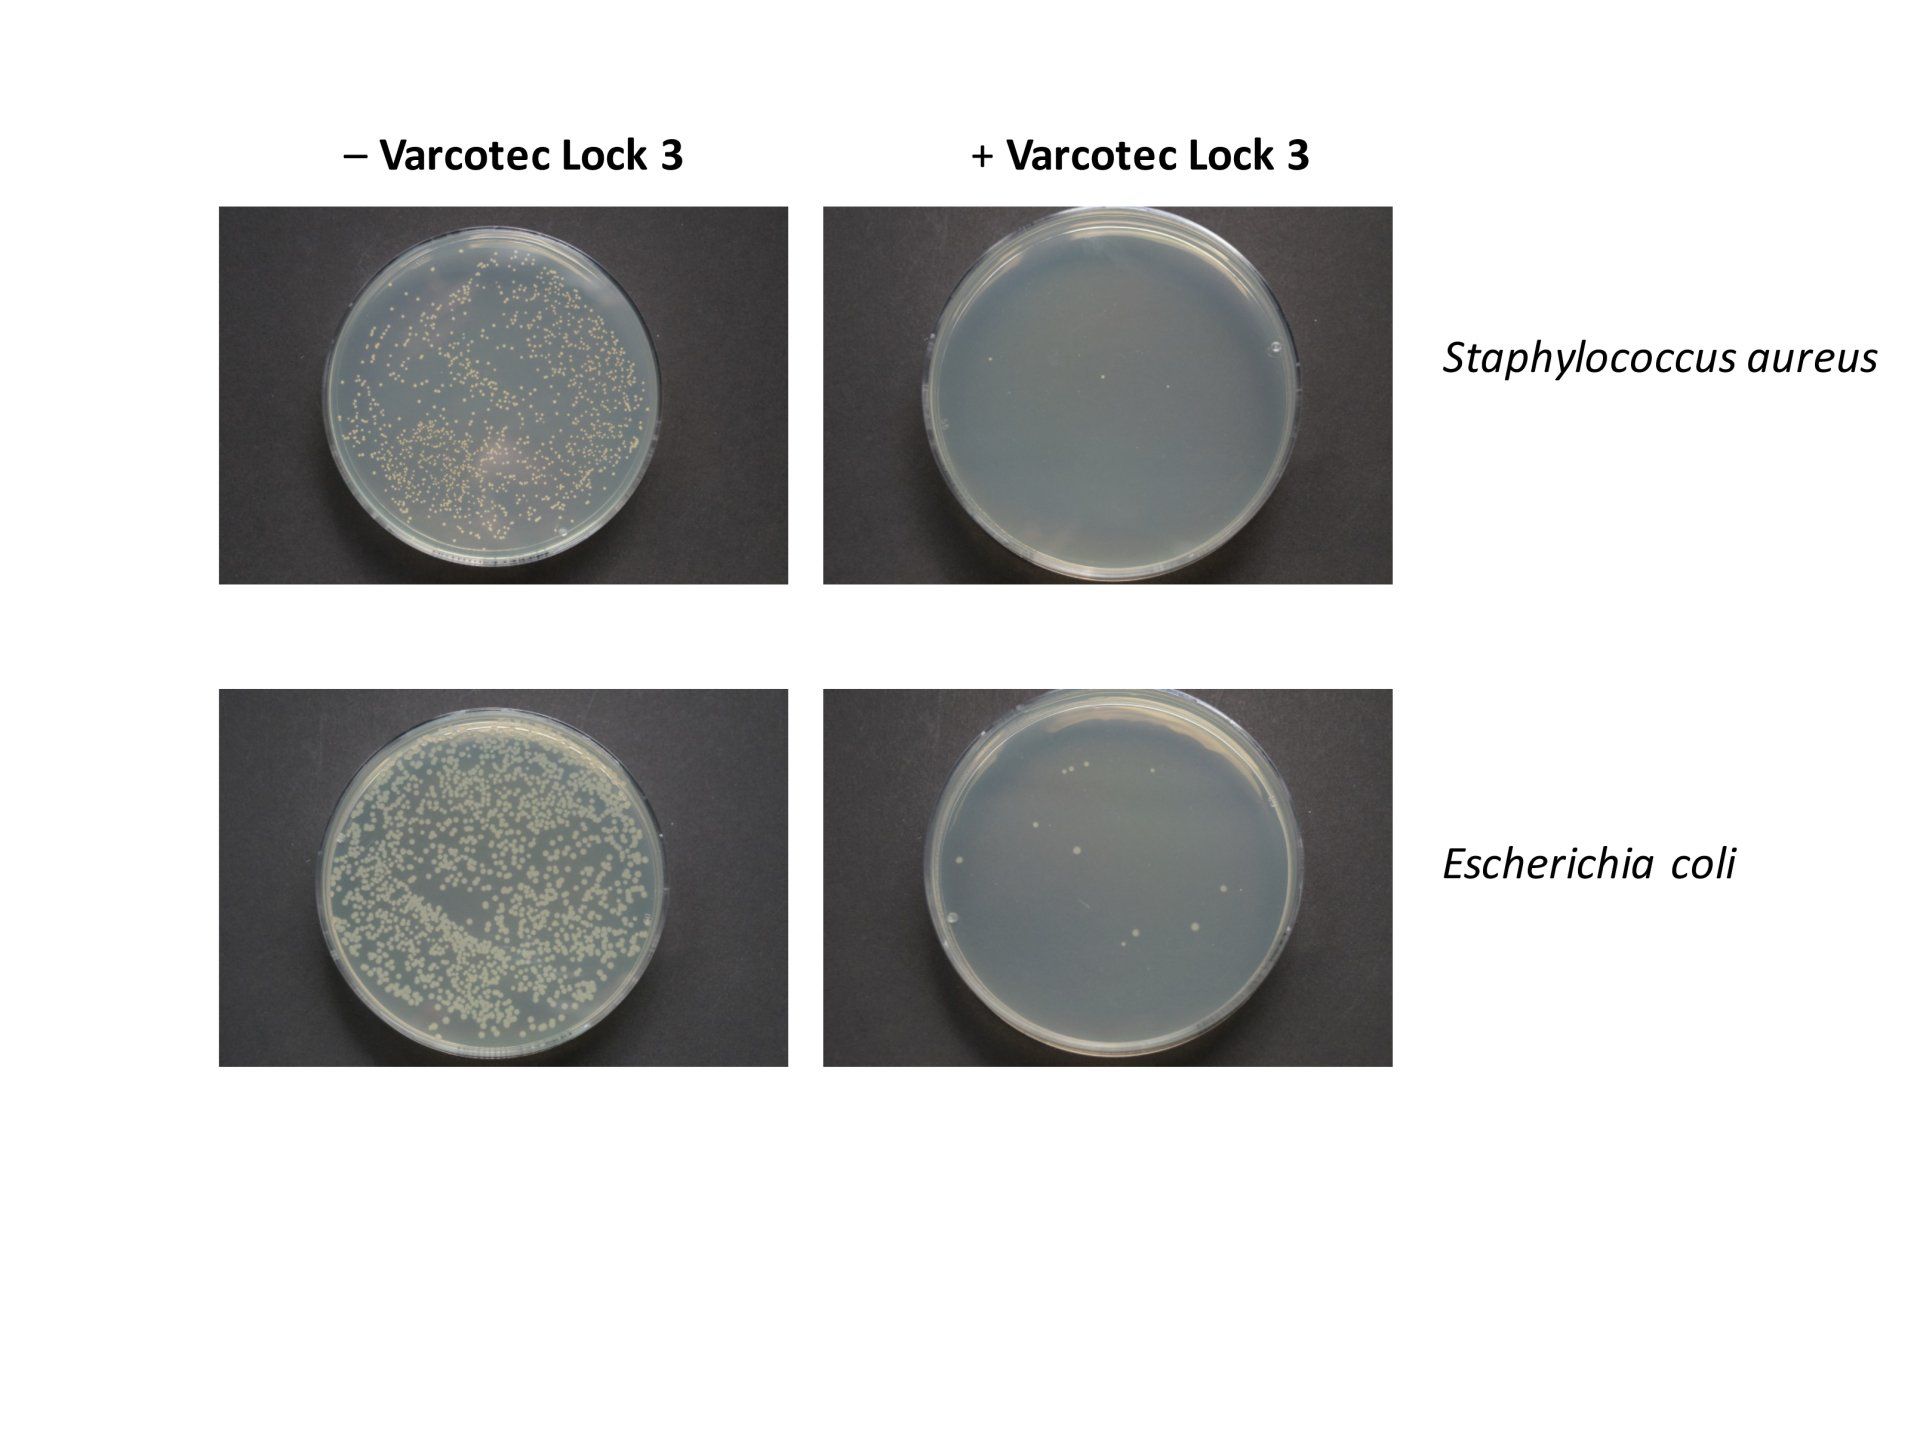

Our Newslettersubscribe
Varcotec Lock 3 antimicrobial water based varnish
Closing hygiene gaps with
Lock 3
Antimicrobial water
based varnish
Free
of
silver and toxic biocides
• requires no harmful UV radiation, only visible light
• Lock 3 shows a reduction of microorganisms already under
indoor lighting conditions (99.99%)
• Formation of resistance of microorganisms against singlet oxygen is not yet known and not to be expected
• has a controllable efficiency depending on the light intensity
• works on dry surfaces
• does not contain toxic or
mutagenic components
• does not release toxic chemicals into the environment
• does not produce odour or aerosol formation

Lock 3
We are pleased to present our latest development to you: Varcotec, Lock 3 - the first antimicrobial water based varnish for the graphic industry. This invention is unique in the world and has a highly effective antimicrobial function for the most diverse types of printed matters. Until today, it has not been possible to apply a reliable varnish to absorbing materials such as paper and cardboard that continuously and permanently kills germs and sustainably increases the security of printed matters. We have now achieved this in a joint development with a German university.
Info Flyer
Certificates

Reference quotes
Kroha GmbH Faltschachtelwerke is a European well-established manufacturer and system supplier for healthcare, beauty and the consumer industry for folding cartons and leaflets.
Certified according to DIN ISO 9001: 2015/50001: 2001 /
FSC / PEFC
The Lock 3 water based varnish we tested in the project was indistinguishable from conventional, certified varnishes in terms of processing and drying behavior.
The application of Lock 3 can thus be used in any water based coating unit. We are proud to have contributed our part to the development of Lock 3 and thus we are in the position to offer Lock 3 to our customers. We at Kroha GmbH Faltschachtel Werke see us as partners in future- oriented production / product developments and see Varcotec Lock 3 as the most innovative solution of this century.
Christoph Kreiser
Managing Director of Kroha GmbH
Reference quotes
We are a traditional printing company in the heart of the Rhine-Neckar metropolitan region here are our roots. This is where our extensive, excellent network grows.
We offer our customers classic print products, but also creative innovations in the areas of print and new media
We print climate-neutral and standardized according to ISO 12647-2 (process standard offset printing) to achieve consistently best print quality.
All management and production processes are maximally quality-optimized.
Together with Varcotec, abcdruck was one of the first printers to carry out the Printing test with the Lock 3 antimicrobial water based varnish.
The drying behavior and the processing do not differ from the known very good varnish properties of Varcotec.
We congratulate Varcotec to the great Innovation Lock 3
Natalie Rothermel
Manager abcdruck LTD
Oliver Lessing
Technical Manager abcdruck LTD



Reference quotes
Trust is, ...
Renowned customers have been entrusting us with the production of their print media
for years, sometimes for decades. The resulting sheer infinite wealth of experience
offers you great potential for embracing this knowledge and the resulting competence.
It is always a good moment to start a long-term, successful and reliable cooperation.
Some companies buy their references, we work it for us ...
„The Varcotec Lock 3 antimicrobial water based varnish can be used without any
problems.
The production of the current cover of the magazine Druck & Medien was a great test
under real production conditions.
Even with longer runs, a stable production is absolutely guaranteed.
We at K W consider the antimicrobial dispersion varnish Lock 3 to be a great innovation
in the truest sense a smooth thing and recommend him gladly.“
Frank Pieper
Executive Director
Kunst- und Werbedruck GmbH & Co KG
Lock 3
Germs can be found on all types of surfaces and of course also on printed matter. Whether packaging, banknotes or playing cards, everything that is passed through multiple hands potentially serves as a "transporter" for germs such as bacteria, viruses or fungi. These can also include germs that can cause serious illnesses.
A big challenge was the development of a special test protocol to prove the effect and the function of Varcotec Lock 3 . This task was carried out by the Fraunhofer Institute. They tested and confirmed.
The range of applications for such a coating / varnish for printed products is very broad and can be used for menu cards, playing cards, hygiene products, packaging for children and infants, food packaging, pharmaceutical packaging, etc.